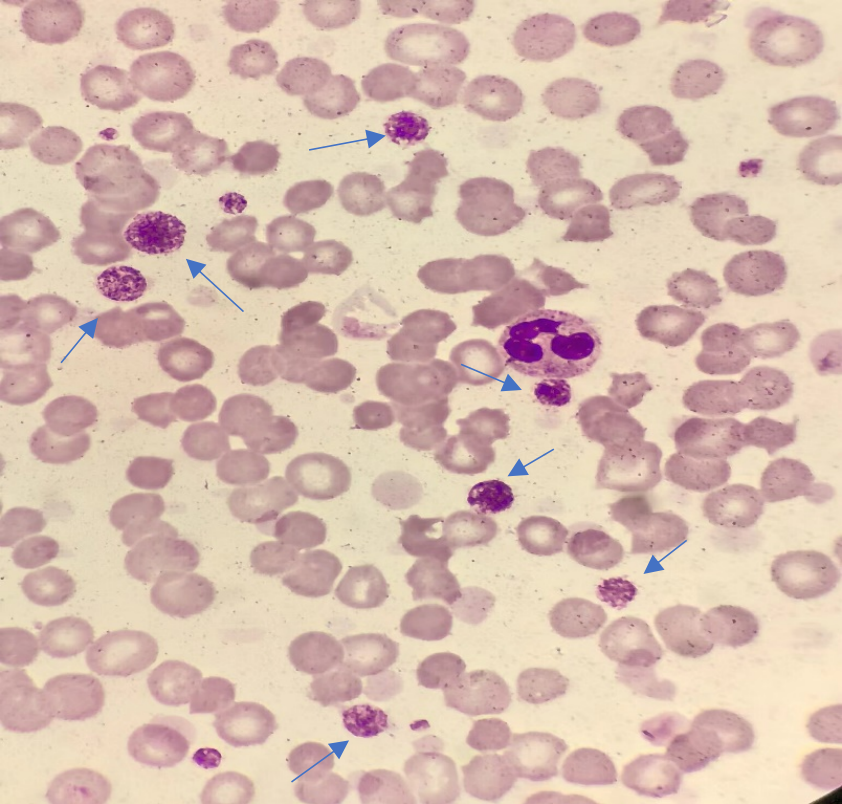
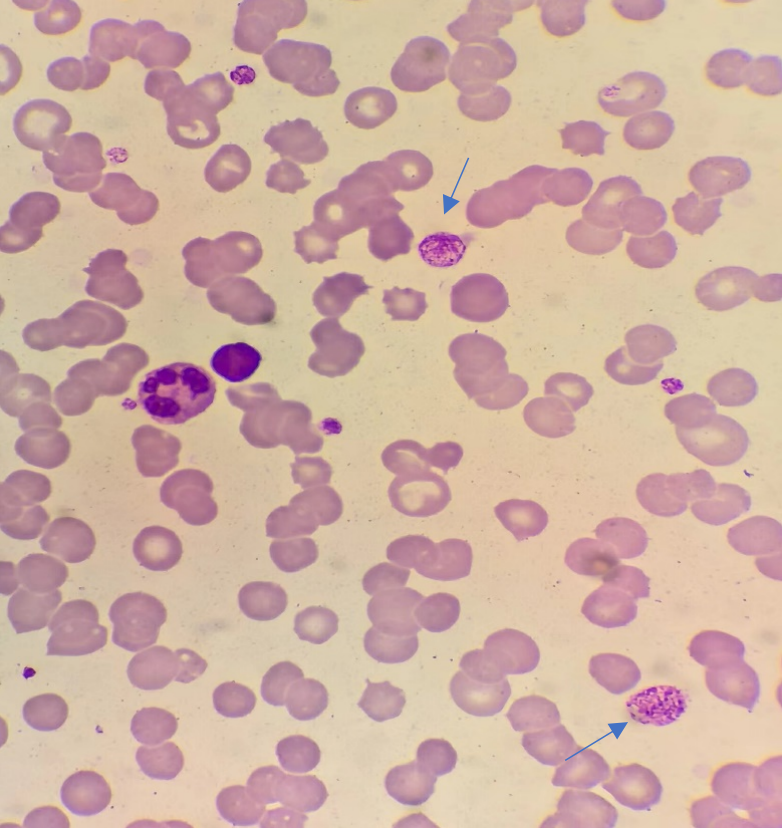

单位 | 怀化市中医医院
01 前 言
我们在日常工作中经常会遇到血小板减少的情况,没有鉴别准确的话,就会给临床的诊断带来难度,甚至是贻误治疗。因此,熟练掌握能够引发真性血小板减低的各类病症与引发血小板计数假性降低的各类因素,借助全自动血液分析仪中所出现的报警提醒、异常的散点图和血小板直方图,联合牛鲍氏计数板、血涂片镜检检测血小板各类形态与其数量,提升细胞形态学检测在临床中的运用,能够精准地对引发血小板减少的各类病因加以诊断,防范产生误诊,对最后治疗方式的选择与病症预后评判而言均十分关键。
常见的引起血小板计数假性减少的原因有以下几种:采血不当所致、EDTA依赖性血小板假性减少症、严重的冷凝集现象影响血小板计数、血小板卫星现象、仪器未把大/巨大血小板计数在内等等因素,大/巨大血小板就是引起本案例中患者血小板假性减少的主角。在发出准确的血常规报告之前,我们要如何快速地“侦察”到它们的存在呢?
02 案例经过
患者,男,55岁,年轻时为矿工。反复咳嗽10年余,于2009年在市疾控中心诊断为“矽肺二期”。患者13岁时在县医院行“脾脏切除术”,具体原因不详。近1个月来咳嗽症状较前加重,咳黑白相间粘痰、伴胸闷心慌、活动后气促,为求进一步诊治入院。
入院后行血常规检查:

仪器报警信息:WBC Abn Scattergram,PLT Abn Distribution、PLT Clump?
白细胞数为6.21×109/L、血小板结果68×109/L,且都打着星号,提示结果可信度低,PDW、MPV P-LCR、PCT未显示结果。血小板直方图明显异常,表现出曲线分布低且宽、PU>25fl,尾部抬高、呈现锯齿状。红细胞直方图显示正常曲线。
患者血常规WDF散点图与右侧示意图对比,影细胞位置右移且颜色较深,说明该类细胞颗粒较多。

横轴为SSC:它与细胞内部结构复杂程度相关,比如胞浆颗粒的多少。
影细胞区域:为溶血后的成熟红细胞碎片和血小板所在位置。
患者血常规WNR散点图与右侧示意图对比可见,影细胞位置散点明显增多并向上延伸至白细胞所在区域,好似向上翘起的“滑板”。

综合PLT、RBC直方图,WDF、WNR散点图分析,此类细胞为大/巨大血小板可能性大,于是立即行血涂片镜检。
显微镜下的大/巨大血小板:血涂片经Wright-Giemsa染色、自然干燥、点上油镜,映入我们眼帘的便是一颗颗圆滚滚的、胞内颗粒紧密堆砌的血细胞,它们的体积得有成熟红细胞、淋巴细胞一般大。多年从事形态学检验的经验告诉我们,这些正是大/巨大血小板。

血涂镜检R值法:在油镜下至少观察10个视野。血小板估测值=每油镜视野中血小板平均个数×R×109/L。公式中R值又称视野因子,国内专家推荐15。
本实验室未开通PLT-F通道,我们用草酸铵稀释液手工计数和血涂片评估血小板数值两种方法复检后,PLT最终报113×109/L。当然我们也不能忘记一同纠正被巨大血小板影响计数的标记着星号的WBC,最后才能安心发放出相对准确的血常规检验报告单。
03 总 结
血细胞分析仪作为血常规过筛工具为我们检验人大大提升了工作效率,作为基层医学检验工作者,能熟练运用其提供给我们的各项参数、报警信息,养成查看直方图、散点图的好习惯,在建立好的实验室复检规则下,检测结果异常者进行血涂片镜检等等,这些都是十分必要和重要的。当然我们对疾病的认知也不能只停留在单个细胞、一份化验单上,得结合患者的临床症状、病史信息、临床医生的诊疗过程等等综合分析。
知识的获取、能力的提升,都需要绵绵用力、久久为功。我们在学习细胞形态学时也是一样,它需要不断积累经验、不断感悟、不断实践和不断总结与更新。
参考文献:
[1] 李惠卿,赖馨,蔡洁丹,高洪丽,唐万兵.血细胞分析仪计数血小板假性减少原因分析及对策探讨[J].临床和实验医学杂志,2014,09:764-767.
[2] 刘春都.血小板计数假性减低的原因分析[J].临床医药文献电子杂志,2017,83:16279-16280+16282.
[3]李娟.低值血小板检测的方法学评价及影响因素分析:山东大学,2019.
[4]仵高强,晏纪军,崔姣,殷潇潇,王儒意,张博.血涂片复检在血常规检测中的重要性.贵州医药.2021.45(11):1799-1800.